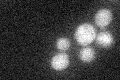
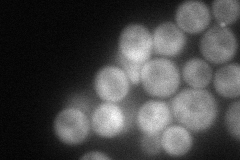
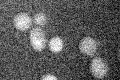

View description
Essential protein that associates with the contractile actomyosin ring, required for ingression of the plasma membrane into the bud neck during cytokinesis; C2 domain, a membrane targeting module, is required for function
Localization:
Intensity:
Fold change:
Significance:
-
C’ GFP library in SD
cytosol21.86 -
N' NOP1pr-GFP in SD

cytosol,bud neck55.4113 -
N' TEF2pr-mCherry in SD
bud neck73.8198 -
N' NATIVEpr-GFP in SD

bud neck18.2006 -
N' TEF2pr-VC and Cyto-VN in SD

cytosol42.5526 -
C’ GFP library in SD+DTT

cytosol23.451.07No -
C’ GFP library in SD+H2O2
cytosol23.421.07No -
C’ GFP library in Starvation Media

cytosol19.790.9No -
C’ GFP library on the background of Pup2-DaMP

cytosol -
C’ GFP library on the background of CCT mutant

cytosol20.04340.916736No
